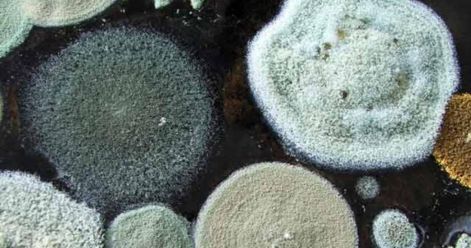
Penészgomba
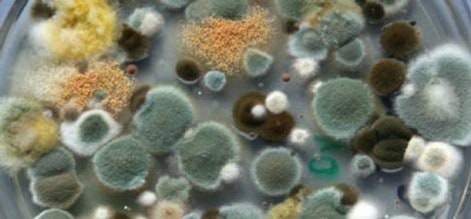
Penészgomba

Penész Stop!
Professzonális penészmentesítés Budapesten!
Penészmentes megoldások
Szüntesse meg a penészesedést egyszer’s mindenkorra!
Penészesedés:
Maga a penészesedés folyamata már mindazokon a felületeken kezdetét veszi, amelyek környezetében a levegőnek három napon át legalább 75% a páratartalma.
Anélkül, hogy a víz a mennyezetről csepegne, vagy az ablaküvegen folyna, avagy az áthidalók a nedvességtől csillognának, már megjelenhet a penész.
Joggal mondhatjuk, hogy a lakáson nem hajtottak végre elégséges penészmentesítést, hogyha a falak hidegebb részein (vagyis a hőhidakon) a festés, vakolat, illetve a tapéta szöveteiben szemmel érzékelhetetlen, piciny vízrészecskék vannak tartósan jelen.
Az emberek háztartási teendőik során folyamatosan főznek, mosnak, szárítanak, virágot locsolnak, stb. –
Mindezeken felül elégségesnek bizonyulhat a penész kialakulásához az a pára is, amelyet légzésünk során bocsájtunk ki – a penészmentesítés tehát minden háztartásban elengedhetetlen.
Penészedésre utaló első jel a kellemetlen, dohos szag.
Ezután következik a telepes elterjedés, amely már szabad szemmel is megfigyelhető – ilyenkor már időszerű elgondolkozni azon, hogyan hajtsuk végre a lakás penészmentesítését.
Mivel a penész egy olyan mikroszkopikus spóraként kezdi fejlődését, amely a légáramlatokkal terjed, ha talál egy számára ideális hőmérséklettel és páratartalommal rendelkező táplálékforrást, akkor fejlődésnek indulhat.
A penész számára a lakáson belüli hőmérséklet minden esetben kielégítő, tehát a penésztelep kialakulása a levegő nedvességtartalmán áll, vagy bukik.
Ez adja a hőhidak, a harmatpont, illetve a páralecsapódás témakörének fontosságát.
Megfelelő penészmentesítés hiányában a penész elél a falon, a tapétán, a szekrény hátoldalán, de akár egy ruhán is éppúgy, mint egy erdőben található fatönkön. Nem csak a régebbi típusú, nedves lakosok penészedhetnek, minden a körültekintően végrehajtott penészmentesítésen múlik.
A penészedés megszüntetésére hozták létre a ThermoVital beltéri penészmentes bevonatott.
ThermoVital:
Forgalmazója: www.thermoshield.hu
Termék partner: www.festek-lotz.hu
A golyók közötti kötőanyagnak fontos szerepe van. Mikor a falat nedvesség éri, a kötőanyag pórusai kitágulnak, és „csapdába” ejtik a párát. Miután a páratartalom alacsony lesz, a „rabul ejtett” vizet, a gyanta „kilélegzi.
Mért adatok bizonyítják, hogy a ThermoVital beltéri penészmentes bevonat képes tökéletesen szabályozni a szoba levegőjének páratartalmát, és 55% körüli értéken tartani azt. A bevonat így gondoskodik arról a kívánatos körülményről, hogy a falfelületen sohasem legyen nedvesség.
Bizonyára Ön is megfigyelte, hogy szellőztetés után milyen gyorsan felmelegszik a friss, száraz levegő. Ennek fizikai magyarázata, hogy nem kell a levegő víztartalmát is fűteni. Ez a tapasztalat azt is bizonyítja, ha alacsonyabban tartom a szobáim páratartalmát, csökken a fűtési költségem. Ez is egy része a bevonat komplex fűtésköltség csökkentő hatásának.
Mi van akkor, ha a bevonatban felszaporodik a „rabul ejtett” pára, és egy darabig leadni sem képes azt? A bevonat kötőanyagában van egy speciális só adalék, ami a nedvesség hatására beleolvad a vízbe. A só – mint ismert konzerválószer – biztosítja a felület penészmentességét. A só nem vegyi anyag, nem párolog el a felületről, a víz eltűnésével visszakerül a bevonat kötőanyagába, várva az újabb „penészölési” lehetőségre.
További információra van szüksége?
Hívjon most! (20) 313-7268